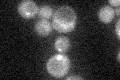
YMR077C
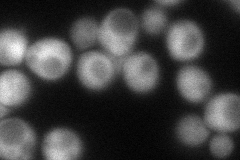
YMR077C
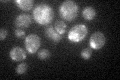
YMR077C

View description
Myristoylated subunit of ESCRTIII, the endosomal sorting complex required for transport of transmembrane proteins into the multivesicular body pathway to the lysosomal/vacuolar lumen; cytoplasmic protein recruited to endosomal membranes
Localization:
Intensity:
Fold change:
Significance:
-
C’ GFP library in SD
punctate23.1 -
N' NOP1pr-GFP in SD

cytosol41.7913 -
N' TEF2pr-mCherry in SD
cytosol68.196 -
N' NATIVEpr-GFP in SD

missing0 -
N' TEF2pr-VC and Cyto-VN in SD

cytosol37.4202 -
C’ GFP library in SD+DTT

punctate22.010.95No -
C’ GFP library in SD+H2O2

punctate15.790.68Yes -
C’ GFP library in Starvation Media
punctate36.871.59Yes -
C’ GFP library on the background of Pup2-DaMP

punctate -
C’ GFP library on the background of CCT mutant

punctate46.96582.0324Yes
